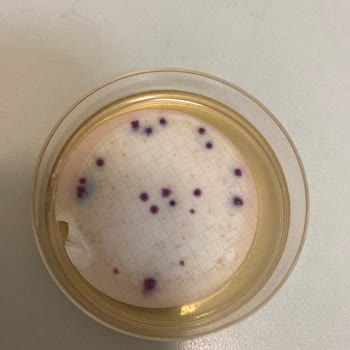
Erikli Su Kalite Ve Kokusu

Erikli Su Şişelerinde Kötü Koku Ve Musluk Suyu Tadı Sorunu Devam Ediyor

Erikli Su markasına ait 1 litrelik ve 0,5 litrelik kapalı pet şişelerde ciddi bir şekilde kötü bir koku ve musluk suyu tadı sorunu yaşıyorum. Bu durumu aylar önce fark ettim, ancak 07.11.2025 tarihinde emin oldum. Bugün 14.11.2025 ve aldığım son 1 litrelik şişede de aynı sorun devam ediyor. Benim dı...